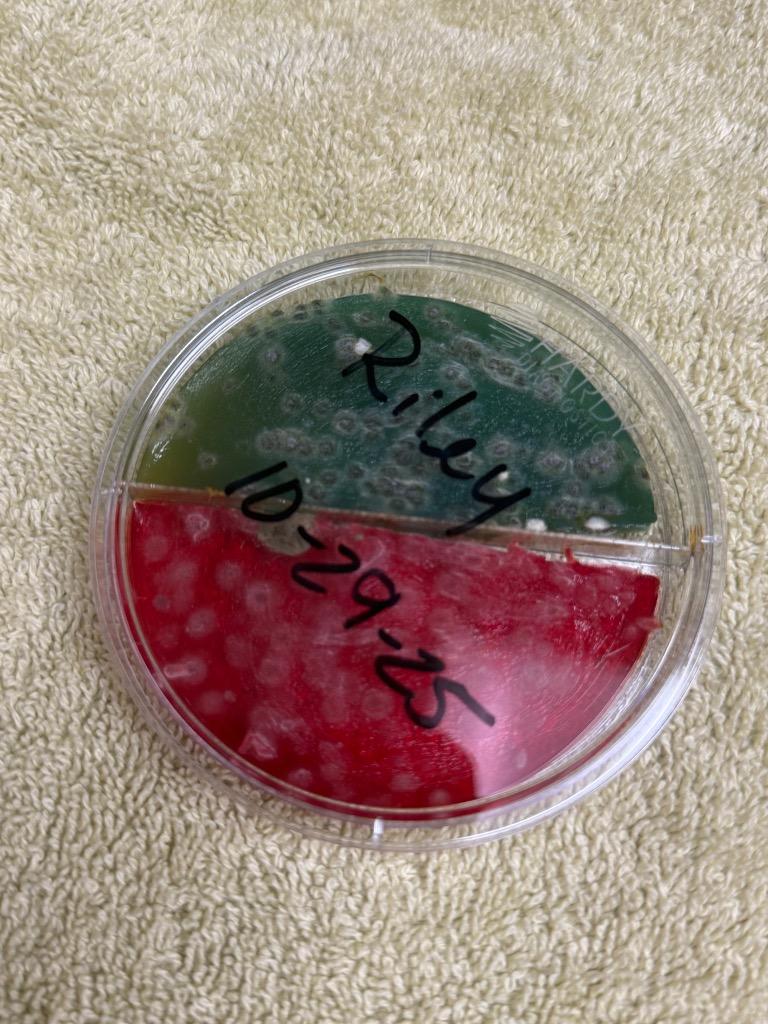
Enlarge RILEY, a Adoptable mixed breed in Wintersville, OH image 2/3

RILEY
- Kitten
- Female
- Medium
- Domestic Short Hair
About RILEY
Wintersville, OH
Breed
Physical Traits
Behavior
Health
RILEY’s Compatibility
This pet has unknown compatibility with kids.
This pet has unknown compatibility with dogs.
This pet has bad compatibility with cats.
This pet has unknown compatibility with other animals.
Adoption Fee
Please contact the shelter about adoption fee
Petfinder recommends that you should always take reasonable security steps before making online payments.
RILEY's Story
Meet Riley -- Over 250 Days and Ready for Her Forever Home.<br/><br/>Riley has been patiently waiting over 250 days for someone to finally notice her, and we think it's about time the world met this tiny ball of personality.<br/><br/>Riley is the perfect mix of sweet and spicy. She can be incredibly snuggly, curling up beside you and purring like a tiny motor, but she's also a playful, energetic kitten who loves adventure. This girl believes every surface is meant to be climbed and every toy deserves to be chased.<br/><br/>She absolutely loves stimulation and playtime, and she would thrive in a home that understands kitten energy and can keep her busy with toys, climbing spaces, and lots of attention.<br/><br/>Riley also has a funny little quirk -- when she gets excited, she'll sometimes purr while giving playful nibbles and grabbing with her paws, which just means she's full of kitten enthusiasm and still learning her manners.<br/><br/>She has recently started meeting other animals after spending time isolated due to ringworm treatment, so she may need slow, patient introductions to new furry friends. With time and understanding, she will continue learning that the world (and other animals) aren't so scary.<br/><br/>After over 250 days of waiting, Riley is more than ready to trade shelter life for a home full of toys, cozy naps, and people who love her big personality as much as we do.<br/><br/>If you're looking for a kitten who will make you laugh, keep you on your toes, and still curl up next to you when she's tired from all her adventures, Riley might just be your girl.<br/>Give us a call at (740) 314-5583 for more information!<br/><br/>ADOPTION APPLICATION:<br/>All adoption applications are completed at the shelter unless otherwise noted.<br/><br/>FOSTER APPLICATION:<br/>Want to be a hero for a homeless animal in need? Apply online to become a Foster Care Volunteer today! https://jeffersoncountyhumanesociety.net/FosterApplication
Meet Riley -- Over 250 Days and Ready for Her Forever Home.
Riley has been patiently waiting over 250 days for someone to finally notice her, and we think it's about time the world met this tiny ball of personality.
Riley is the perfect mix of sweet and spicy. She can be incredibly snuggly, curling up beside you and purring like a tiny motor, but she's also a playful, energetic kitten who loves adventure. This girl believes every surface is meant to be climbed and every toy deserves to be chased.
She absolutely loves stimulation and playtime, and she would thrive in a home that understands kitten energy and can keep her busy with toys, climbing spaces, and lots of attention.
Riley also has a funny little quirk -- when she gets excited, she'll sometimes purr while giving playful nibbles and grabbing with her paws, which just means she's full of kitten enthusiasm and still learning her manners.
She has recently started meeting other animals after spending time isolated due to ringwo
Meet Riley -- Over 250 Days and Ready for Her Forever Home.
Riley has been patiently waiting over 250 days for someone to finally notice her, and we think it's about time the world met this tiny ball of personality.
Riley is the perfect mix of sweet and spicy. She can be incredibly snuggly, curling up beside you and purring like a tiny motor, but she's also a playful, energetic kitten who loves adventure. This girl believes every surface is meant to be climbed and every toy deserves to be chased.
She absolutely loves stimulation and playtime, and she would thrive in a home that understands kitten energy and can keep her busy with toys, climbing spaces, and lots of attention.
Riley also has a funny little quirk -- when she gets excited, she'll sometimes purr while giving playful nibbles and grabbing with her paws, which just means she's full of kitten enthusiasm and still learning her manners.
She has recently started meeting other animals after spending time isolated due to ringworm treatment, so she may need slow, patient introductions to new furry friends. With time and understanding, she will continue learning that the world (and other animals) aren't so scary.
After over 250 days of waiting, Riley is more than ready to trade shelter life for a home full of toys, cozy naps, and people who love her big personality as much as we do.
If you're looking for
Consider RILEY for adoption?
Help with RILEY's care
How To Adopt
RILEY is from Jefferson County Humane Society
[Wintersville, OH]
Consider RILEY for adoption?
Help with RILEY's care